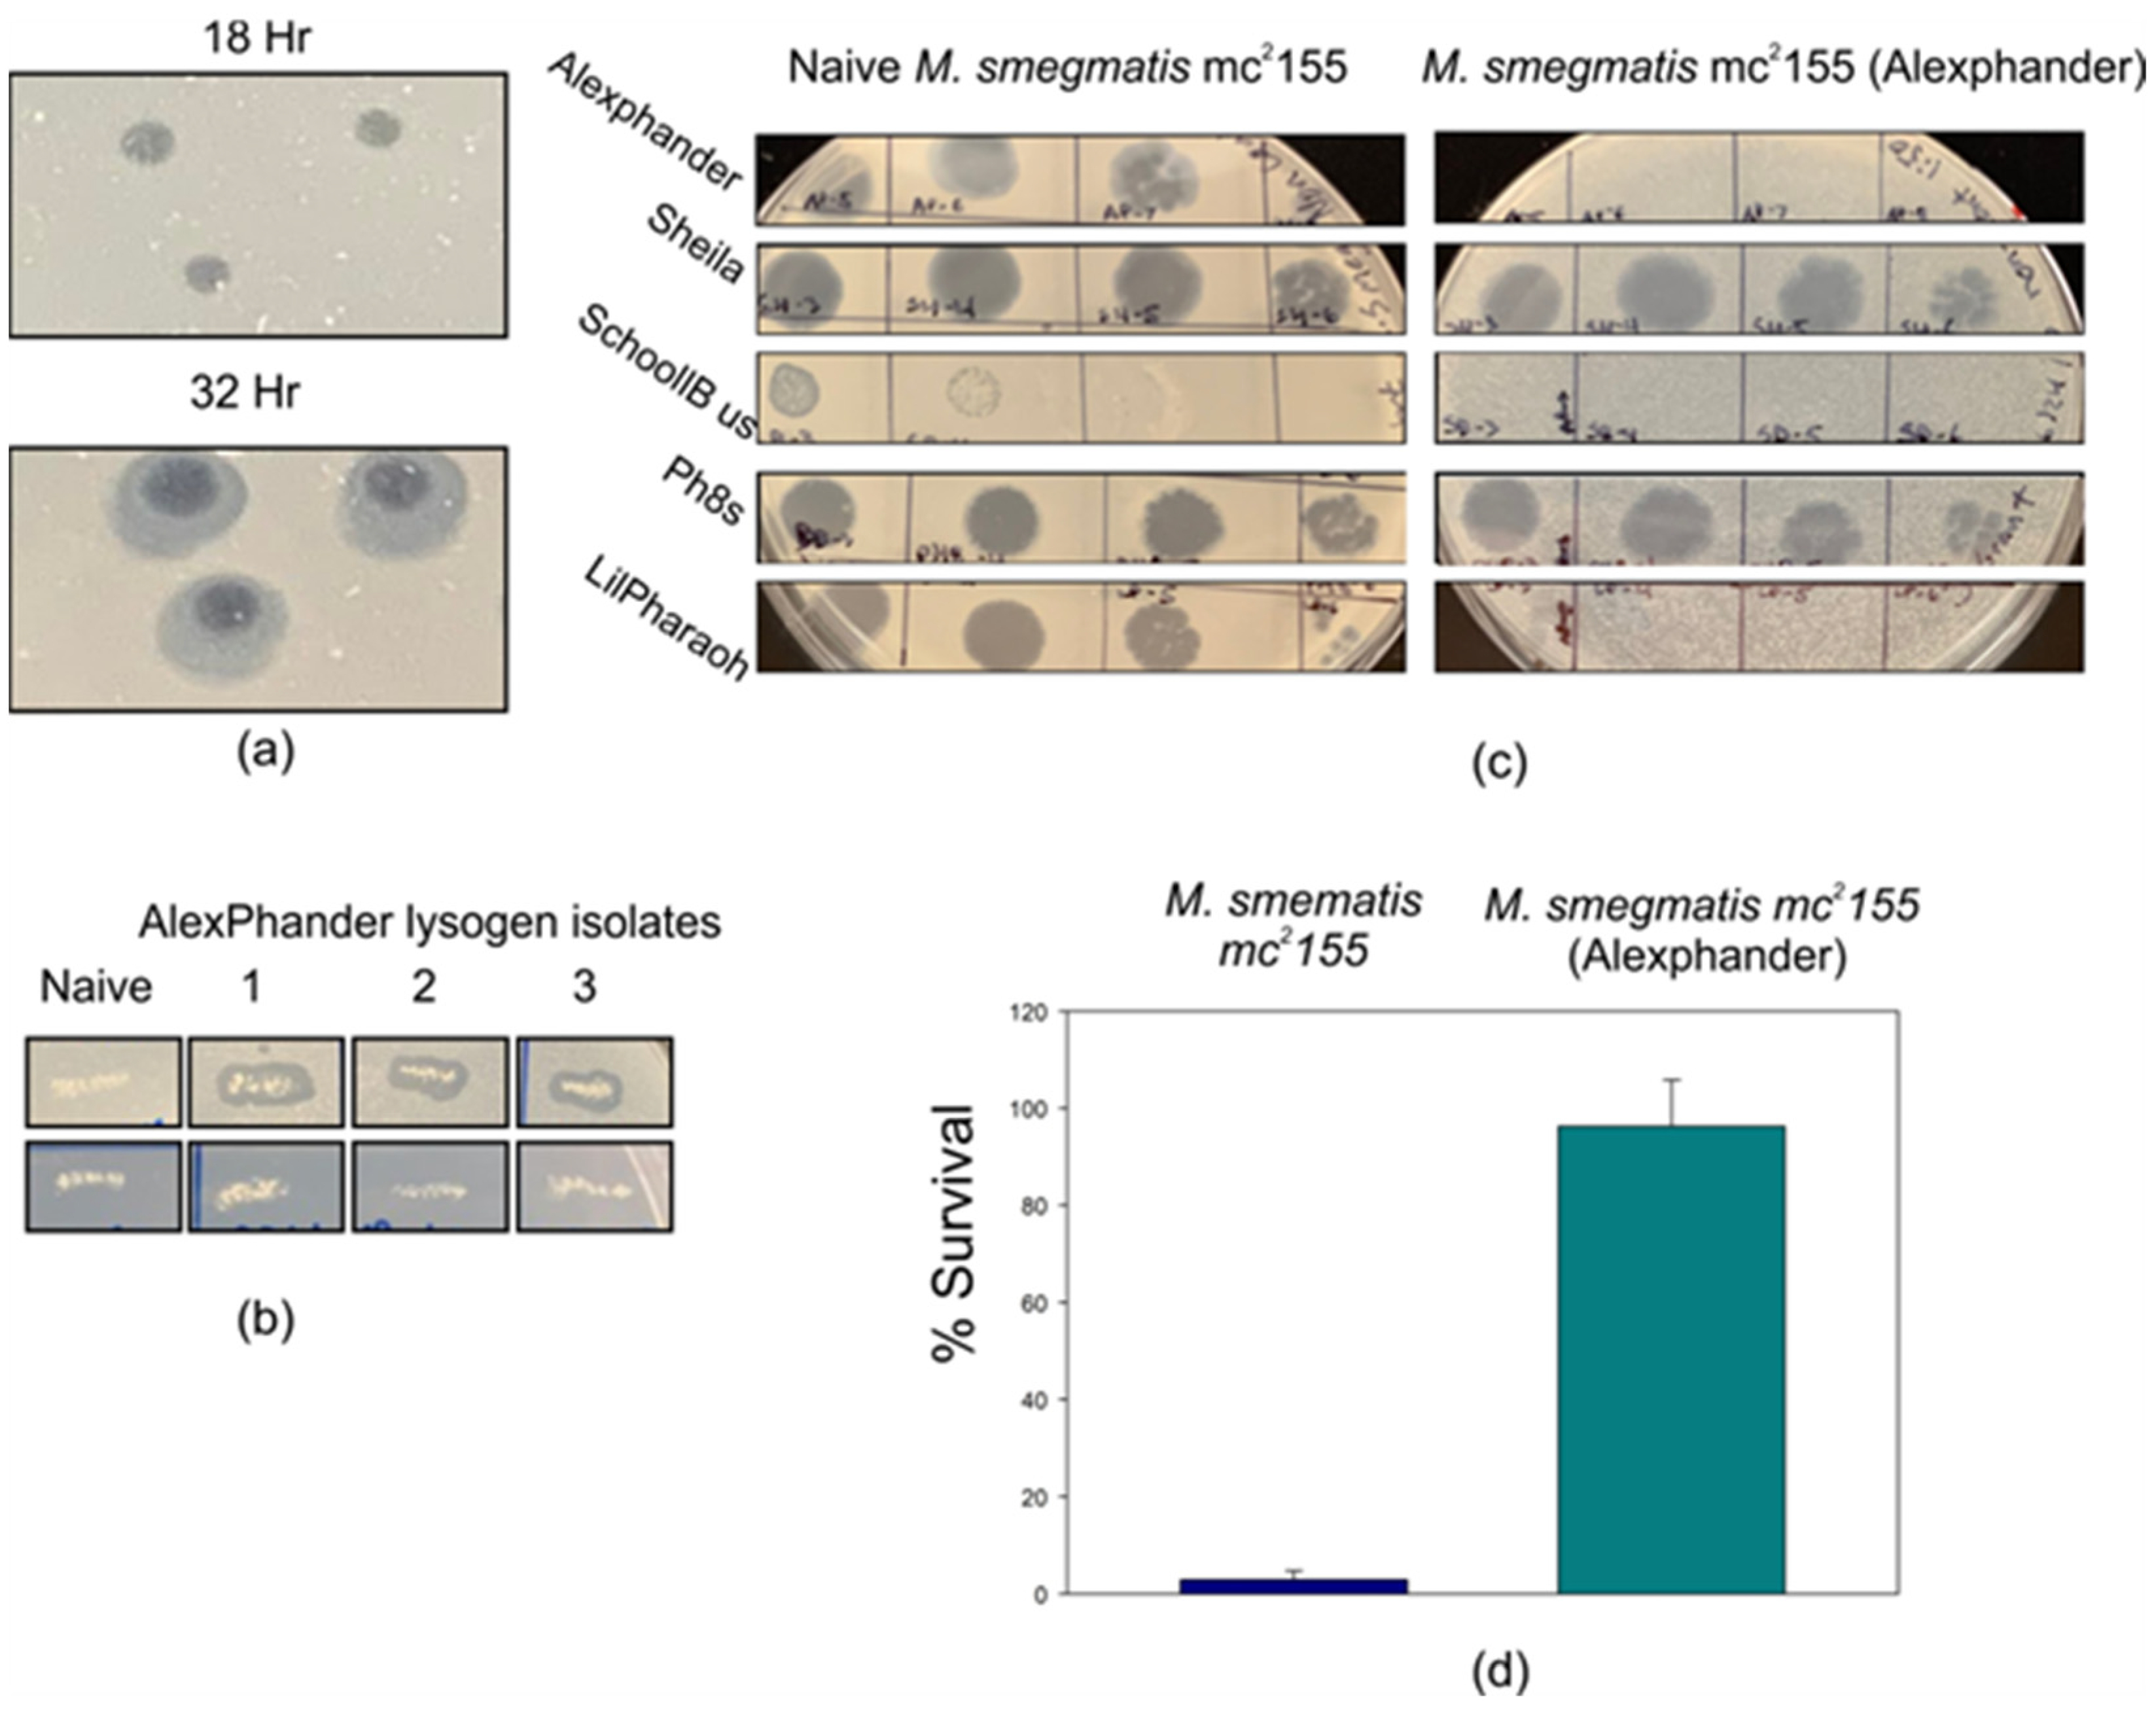
Ijms 25 07466 g001 Ijms 25 07466 g001

Mycobacteriophage Alexphander Gene 94 Encodes an Essential dsDNA-Binding Protein during Lytic Infection
Abstract
1. Introduction
2. Results
2.1. Mycobacteriophage Alexphander Is a Temperate Phage That Forms Stable Lysogens
2.2. Alexphander Gene 94 Orthologs Are Present within Numerous Actinobacteria and Their Phages
2.3. The Mycobacteriophage Alexphander Gene 94 Is Essential for Lytic Alexphander Infection

2.4. Gene 94 Encodes Protein Containing a Putative N-Terminal Metal-Binding Motif and a C-Terminal HTH DNA-Binding Motif
2.5. Gp94 Binds DNA Fragments and Phage Genomic DNA Nonspecifically Generating Cooperative Higher-Order Nucleoprotein Complexes
2.6. Maximum Gene 94 Transcription Occurs Late during Lytic Growth
3. Discussion
4. Materials and Methods
4.1. Strains and Plasmids
4.2. Lysogeny Efficiency
4.3. Constructing the 94 Deletions in Alexphander
4.4. Cloning, Expression, and Purification of Recombinant gp94
4.5. Size-Exclusion Chromatography
4.6. Bioinformatic Analyses
4.7. DNA-Binding Assays
4.8. RNA Analyses
Supplementary Materials
Author Contributions
Funding
Informed Consent Statement
Data Availability Statement
Acknowledgments
Conflicts of Interest
References
- Hatfull, G.F. Mycobacteriophages. Microbiol. Spectr. 2018; 6, 1–32. [Google Scholar] [CrossRef]
- Comeau, A.M.; Hatfull, G.F.; Krisch, H.M.; Lindell, D.; Mann, N.H.; Prangishvili, D. Exploring the prokaryotic virosphere. Res. Microbiol. 2008, 159, 306–313. [Google Scholar] [CrossRef] [PubMed]
- Koskella, B.; Brockhurst, M.A. Bacteria-phage coevolution as a driver of ecological and evolutionary processes in microbial communities. FEMS Microbiol. Rev. 2014, 38, 916–931. [Google Scholar] [CrossRef] [PubMed]
- Johansen, M.D.; Alcaraz, M.; Dedrick, R.M.; Roquet-Banères, F.; Hamela, C.; Hatfull, G.F.; Kremer, L. Mycobacteriophage-antibiotic therapy promotes enhanced clearance of drug-resistant Mycobacterium abscessus. Dis. Model. Mech. 2021, 14, dmm049159. [Google Scholar] [CrossRef] [PubMed]
- Harada, L.K.; Silva, E.C.; Campos, W.F.; Del Fiol, F.S.; Vila, M.; Dąbrowska, K.; Krylov, V.N.; Balcão, V.M. Biotechnological applications of bacteriophages: State of the art. Microbiol. Res. 2018, 212–213, 38–58. [Google Scholar] [CrossRef] [PubMed]
- Keen, E.C. A century of phage research: Bacteriophages and the shaping of modern biology. BioEssays 2015, 37, 6–9. [Google Scholar] [CrossRef] [PubMed]
- Salmond, G.P.; Fineran, P.C. A century of the phage: Past, present and future. Nat. Rev. Microbiol. 2015, 13, 777–786. [Google Scholar] [CrossRef] [PubMed]
- Hatfull, G.F.; Racaniello, V. PHIRE and TWiV: Experiences in Bringing Virology to New Audiences. Annu. Rev. Virol. 2014, 1, 37–53. [Google Scholar] [CrossRef] [PubMed]
- Jordan, T.C.; Burnett, S.H.; Carson, S.; Caruso, S.M.; Clase, K.; DeJong, R.J.; Dennehy, J.J.; Denver, D.R.; Dunbar, D.; Elgin, S.C.; et al. A broadly implementable research course in phage discovery and genomics for first-year undergraduate students. mBio 2014, 5, e01051-13. [Google Scholar] [CrossRef] [PubMed]
- Russell, D.A.; Hatfull, G.F. PhagesDB: The actinobacteriophage database. Bioinformatics 2017, 33, 784–786. [Google Scholar] [CrossRef]
- Morris, P.; Marinelli, L.J.; Jacobs-Sera, D.; Hendrix, R.W.; Hatfull, G.F. Genomic characterization of mycobacteriophage Giles: Evidence for phage acquisition of host DNA by illegitimate recombination. J. Bacteriol. 2008, 190, 2172–2182. [Google Scholar] [CrossRef]
- Dedrick, R.M.; Marinelli, L.J.; Newton, G.L.; Pogliano, K.; Pogliano, J.; Hatfull, G.F. Functional requirements for bacteriophage growth: Gene essentiality and expression in mycobacteriophage Giles. Mol. Microbiol. 2013, 88, 577–589. [Google Scholar] [CrossRef] [PubMed]
- Mehla, J.; Dedrick, R.M.; Caufield, J.H.; Siefring, R.; Mair, M.; Johnson, A.; Hatfull, G.F.; Uetz, P. The Protein Interactome of Mycobacteriophage Giles Predicts Functions for Unknown Proteins. J. Bacteriol. 2015, 197, 2508–2516. [Google Scholar] [CrossRef] [PubMed][Green Version]
- Hutinet, G.; Kot, W.; Cui, L.; Hillebrand, R.; Balamkundu, S.; Gnanakalai, S.; Neelakandan, R.; Carstens, A.B.; Fa Lui, C.; Tremblay, D.; et al. 7-Deazaguanine modifications protect phage DNA from host restriction systems. Nat. Commun. 2019, 10, 5442. [Google Scholar] [CrossRef]
- Ko, C.C.; Hatfull, G.F. Identification of mycobacteriophage toxic genes reveals new features of mycobacterial physiology and morphology. Sci. Rep. 2020, 10, 14670. [Google Scholar] [CrossRef]
- McGinnis, R.J.; Brambley, C.A.; Stamey, B.; Green, W.C.; Gragg, K.N.; Cafferty, E.R.; Terwilliger, T.C.; Hammel, M.; Hollis, T.J.; Miller, J.M.; et al. A monomeric mycobacteriophage immunity repressor utilizes two domains to recognize an asymmetric DNA sequence. Nat. Commun. 2022, 13, 4105. [Google Scholar] [CrossRef] [PubMed]
- Schumacher, M.A.; Lee, J.; Zeng, W. Molecular insights into DNA binding and anchoring by the Bacillus subtilis sporulation kinetochore-like RacA protein. Nucleic Acids Res. 2016, 44, 5438–5449. [Google Scholar] [CrossRef]
- Changela, A.; Chen, K.; Xue, Y.; Holschen, J.; Outten, C.E.; O'Halloran, T.V.; Mondragón, A. Molecular Basis of Metal-Ion Selectivity and Zeptomolar Sensitivity by CueR. Science 2003, 301, 1383–1387. [Google Scholar] [CrossRef] [PubMed]
- Cornelissen, A.; Ceyssens, P.J.; T'Syen, J.; Van Praet, H.; Noben, J.P.; Shaburova, O.V.; Krylov, V.N.; Volckaert, G.; Lavigne, R. The T7-related Pseudomonas putida phage phi15 displays virion-associated biofilm degradation properties. PLoS ONE 2011, 6, e18597. [Google Scholar] [CrossRef]
- Fernandes, S.; Sao-Jose, C. Enzymes and Mechanisms Employed by Tailed Bacteriophages to Breach the Bacterial Cell Barriers. Viruses 2018, 10, 396. [Google Scholar] [CrossRef]
- Pham, T.T.; Jacobs-Sera, D.; Pedulla, M.L.; Hendrix, R.W.; Hatfull, G.F. Comparative genomic analysis of mycobacteriophage Tweety: Evolutionary insights and construction of compatible site-specific integration vectors for mycobacteria. Microbiology 2007, 153, 2711–2723. [Google Scholar] [CrossRef]
- Cresawn, S.G.; Bogel, M.; Day, N.; Jacobs-Sera, D.; Hendrix, R.W.; Hatfull, G.F. Phamerator: A bioinformatic tool for comparative bacteriophage genomics. BMC Bioinform. 2011, 12, 395. [Google Scholar] [CrossRef] [PubMed]
- Troshin, P.V.; Procter, J.B.; Barton, G.J. Java bioinformatics analysis web services for multiple sequence alignment--JABAWS:MSA. Bioinformatics 2011, 27, 2001–2002. [Google Scholar] [CrossRef] [PubMed]
- Marinelli, L.J.; Piuri, M.; Swigonova, Z.; Balachandran, A.; Oldfield, L.M.; van Kessel, J.C.; Hatfull, G.F. BRED: A simple and powerful tool for constructing mutant and recombinant bacteriophage genomes. PLoS ONE 2008, 3, e3957. [Google Scholar] [CrossRef] [PubMed]
- van Kessel, J.C.; Hatfull, G.F. Recombineering in Mycobacterium tuberculosis. Nat. Methods 2007, 4, 147–152. [Google Scholar] [CrossRef] [PubMed]
- Gasteiger, E.; Gattiker, A.; Hoogland, C.; Ivanyi, I.; Appel, R.D.; Bairoch, A. ExPASy: The proteomics server for in-depth protein knowledge and analysis. Nucleic Acids Res. 2003, 31, 3784–3788. [Google Scholar] [CrossRef] [PubMed]
- Webb, B.; Sali, A. Comparative Protein Structure Modeling Using MODELLER. Curr. Protoc. Bioinform. 2014, 47, 1–32. [Google Scholar] [CrossRef] [PubMed]
- Jumper, J.; Evans, R.; Pritzel, A.; Green, T.; Figurnov, M.; Ronneberger, O.; Tunyasuvunakool, K.; Bates, R.; Zidek, A.; Potapenko, A.; et al. Highly accurate protein structure prediction with AlphaFold. Nature 2021, 596, 583–589. [Google Scholar] [CrossRef] [PubMed]
- Verdonk, C.J.; Marshall, A.C.; Ramsay, J.P.; Bond, C.S. Crystallographic and X-ray scattering study of RdfS, a recombination directionality factor from an integrative and conjugative element. Acta Crystallogr. Sect. D 2022, 78, 1210–1220. [Google Scholar] [CrossRef] [PubMed]
- Fillol-Salom, A.; Bacarizo, J.; Alqasmi, M.; Ciges-Tomas, J.R.; Martinez-Rubio, R.; Roszak, A.W.; Cogdell, R.J.; Chen, J.; Marina, A.; Penades, J.R. Hijacking the Hijackers: Escherichia coli Pathogenicity Islands Redirect Helper Phage Packaging for Their Own Benefit. Mol. Cell 2019, 75, 1020–1030.e4. [Google Scholar] [CrossRef]
- Holm, L.; Laiho, A.; Toronen, P.; Salgado, M. DALI shines a light on remote homologs: One hundred discoveries. Protein Sci. 2023, 32, e4519. [Google Scholar] [CrossRef]
- Zhang, J.; Zhao, L.; Seo, H.S.; Jung, J.H.; Choi, J.I.; Kim, M.K.; Lim, S. Crystal structure of the highly radiation-inducible DinB/YfiT superfamily protein DR0053 from Deinococcus radiodurans R1. Biochem. Biophys. Res. Commun. 2019, 513, 354–359. [Google Scholar] [CrossRef]
- Yan, J.; Kurgan, L. DRNApred, fast sequence-based method that accurately predicts and discriminates DNA- and RNA-binding residues. Nucleic Acids Res. 2017, 45, e84. [Google Scholar] [CrossRef]
- Cho, E.H.; Alcaraz, R., Jr.; Gumport, R.I.; Gardner, J.F. Characterization of bacteriophage lambda excisionase mutants defective in DNA binding. J. Bacteriol. 2000, 182, 5807–5812. [Google Scholar] [CrossRef] [PubMed][Green Version]
- Hancock, S.P.; Cascio, D.; Johnson, R.C. Cooperative DNA binding by proteins through DNA shape complementarity. Nucleic Acids Res. 2019, 47, 8874–8887. [Google Scholar] [CrossRef] [PubMed]
- Zhang, Y.; Skolnick, J. TM-align: A protein structure alignment algorithm based on the TM-score. Nucleic Acids Res. 2005, 33, 2302–2309. [Google Scholar] [CrossRef] [PubMed]
- The PyMOL Molecular Graphics System, Version 2.0; Schrödinger, LLC: New York, NY, USA, 2015.
- Larkin, M.A.; Blackshields, G.; Brown, N.P.; Chenna, R.; McGettigan, P.A.; McWilliam, H.; Valentin, F.; Wallace, I.M.; Wilm, A.; Lopez, R.; et al. Clustal W and Clustal X version 2.0. Bioinformatics 2007, 23, 2947–2948. [Google Scholar] [CrossRef]
- Singh, S.; Sevalkar, R.R.; Sarkar, D.; Karthikeyan, S. Characteristics of the essential pathogenicity factor Rv1828, a MerR family transcription regulator from Mycobacterium tuberculosis. FEBS J. 2018, 285, 4424–4444. [Google Scholar] [CrossRef]
- Brown, N.L.; Stoyanov, J.V.; Kidd, S.P.; Hobman, J.L. The MerR family of transcriptional regulators. FEMS Microbiol. Rev. 2003, 27, 145–163. [Google Scholar] [CrossRef]
- Lund, P.A.; Brown, N.L. Regulation of transcription in Escherichia coli from the mer and merR promoters in the transposon Tn501. J. Mol. Biol. 1989, 205, 343–353. [Google Scholar] [CrossRef]
- Kalichuk, V.; Behar, G.; Renodon-Corniere, A.; Danovski, G.; Obal, G.; Barbet, J.; Mouratou, B.; Pecorari, F. The archaeal "7 kDa DNA-binding" proteins: Extended characterization of an old gifted family. Sci. Rep. 2016, 6, 37274. [Google Scholar] [CrossRef]
- Bhowmik, D.; Du, M.; Tian, Y.; Ma, S.; Wu, J.; Chen, Z.; Yin, Q.; Zhu, F. Cooperative DNA binding mediated by KicGAS/ORF52 oligomerization allows inhibition of DNA-induced phase separation and activation of cGAS. Nucleic Acids Res. 2021, 49, 9389–9403. [Google Scholar] [CrossRef] [PubMed]
- Ko, C.C.; Hatfull, G.F. Mycobacteriophage Fruitloop gp52 inactivates Wag31 (DivIVA) to prevent heterotypic superinfection. Mol. Microbiol. 2018, 108, 443–460. [Google Scholar] [CrossRef] [PubMed]
- Owen, S.V.; Wenner, N.; Dulberger, C.L.; Rodwell, E.V.; Bowers-Barnard, A.; Quinones-Olvera, N.; Rigden, D.J.; Rubin, E.J.; Garner, E.C.; Baym, M.; et al. Prophages encode phage-defense systems with cognate self-immunity. Cell Host. Microbe 2021, 29, 1620–1633.e8. [Google Scholar] [CrossRef] [PubMed]
- Bondy-Denomy, J.; Qian, J.; Westra, E.R.; Buckling, A.; Guttman, D.S.; Davidson, A.R.; Maxwell, K.L. Prophages mediate defense against phage infection through diverse mechanisms. ISME J. 2016, 10, 2854–2866. [Google Scholar] [CrossRef] [PubMed]
- Montgomery, M.T.; Guerrero Bustamante, C.A.; Dedrick, R.M.; Jacobs-Sera, D.; Hatfull, G.F. Yet More Evidence of Collusion: A New Viral Defense System Encoded by Gordonia Phage CarolAnn. mBio 2019, 10, e02417-18. [Google Scholar] [CrossRef] [PubMed]
- Gentile, G.M.; Wetzel, K.S.; Dedrick, R.M.; Montgomery, M.T.; Garlena, R.A.; Jacobs-Sera, D.; Hatfull, G.F. More Evidence of Collusion: A New Prophage-Mediated Viral Defense System Encoded by Mycobacteriophage Sbash. mBio 2019, 10, e00196-19. [Google Scholar] [CrossRef] [PubMed]
- Dedrick, R.M.; Jacobs-Sera, D.; Bustamante, C.A.G.; Garlena, R.A.; Mavrich, T.N.; Pope, W.H.; Reyes, J.C.C.; Russell, D.A.; Adair, T.; Alvey, R.; et al. Prophage-mediated defence against viral attack and viral counter-defence. Nat. Microbiol. 2017, 2, 16251. [Google Scholar] [CrossRef] [PubMed]
- Hobman, J.L. MerR family transcription activators: Similar designs, different specificities. Mol. Microbiol. 2007, 63, 1275–1278. [Google Scholar] [CrossRef] [PubMed]
- Julian, D.J.; Kershaw, C.J.; Brown, N.L.; Hobman, J.L. Transcriptional activation of MerR family promoters in Cupriavidus metallidurans CH34. Antonie Van Leeuwenhoek 2009, 96, 149–159. [Google Scholar] [CrossRef]
- Gibson, D.G.; Young, L.; Chuang, R.Y.; Venter, J.C.; Hutchison, C.A., 3rd; Smith, H.O. Enzymatic assembly of DNA molecules up to several hundred kilobases. Nat. Methods 2009, 6, 343–345. [Google Scholar] [CrossRef]
- Bradford, M.M. A rapid and sensitive method for the quantitation of microgram quantities of protein utilizing the principle of protein-dye binding. Anal. Biochem. 1976, 72, 248–254. [Google Scholar] [CrossRef] [PubMed]
- Schaffer, A.A.; Aravind, L.; Madden, T.L.; Shavirin, S.; Spouge, J.L.; Wolf, Y.I.; Koonin, E.V.; Altschul, S.F. Improving the accuracy of PSI-BLAST protein database searches with composition-based statistics and other refinements. Nucleic Acids Res. 2001, 29, 2994–3005. [Google Scholar] [CrossRef] [PubMed]
- Sievers, F.; Higgins, D.G. The Clustal Omega Multiple Alignment Package. Methods Mol. Biol. 2021, 2231, 3–16. [Google Scholar] [CrossRef] [PubMed]
- Soding, J.; Biegert, A.; Lupas, A.N. The HHpred interactive server for protein homology detection and structure prediction. Nucleic Acids Res. 2005, 33, W244–W248. [Google Scholar] [CrossRef] [PubMed]
- Koressaar, T.; Lepamets, M.; Kaplinski, L.; Raime, K.; Andreson, R.; Remm, M. Primer3_masker: Integrating masking of template sequence with primer design software. Bioinformatics 2018, 34, 1937–1938. [Google Scholar] [CrossRef]
- Koressaar, T.; Remm, M. Enhancements and modifications of primer design program Primer3. Bioinformatics 2007, 23, 1289–1291. [Google Scholar] [CrossRef]

| Plasmid Name | Description | Source |
|---|---|---|
| pET11a | Parent expression strain | Novagen |
| pJV53 | BRED recombineering plasmid | Van Kessel et al., 2007 [25] |
| pLAM12 | Acetamide inducible complementation plasmid—parent | Marinelli et al., 2008 [24] |
| pSH11 | pETt11a with N-HIS gp94 cloned downstream of the T7 promoter | This study |
| pSH20 | Gene 94 complementation plasmid—acetamide inducible | This study constructed from pLAM12 [24] |
| Purpose | Sequence | |
|---|---|---|
| Flanking PCR recombinant screening | ||
| Forward primer | gttgtgcagtctgaacccaaccagg | |
| Reverse primer | gaccacaaacccgttcgctaagtg | |
| Gene 94 deletion substrate | tgccccattcaagaccctgacgagcaccgggcgttctgccaactccaagcagacatctacgcccacctcgccgacgtcccggcagaggtcggcgttgccgcagcggaactgctcgaacgccgcgagaaggaacgacgggaacagaaagcgatgttcaggaaggcattcgacaagtgagcatggacttccacctccccaggtctgaacaggtaagattagcagaatgagccgggtctttcgggtgcatctcaacgacgtcctcgctgcggaatgctgccaccccaactgctacgcgccagcccttactgacatagccagtcatgtgccgttgtgtgagcggcacatcatggttgtctaccgggaagccaatctcatgctcgccagccatagagctatggaa | |
| Deletion substrate amplification. Forward primer | ||
| tgccccattcaagaccc | ||
| Reverse primer | ttccatagctctatggctgg | |
| Gibson assembly of Δ94 complementation construct | ||
| Primer I1 | gagatcggcggccgcatatgagcatggacttccacc | |
| Primer I2 | gtcggaattcgccggggcgctcattctgctaatcttacct | |
| Primer O1 | aggtaagattagcagaatgagcgccccggcgaattc | |
| Primer O2 | gggaggtggaagtccatgctcatatgcggccgccgatctc | |
| Gibson assembly of full-length gp94 expression construct | ||
| Primer I1 | ttaagaaggagatatacatatgcatcatcaccatcaccacagcatggacttccacctcc | |
| Primer I2 | ctgtccaccagtcatgctagctcattctgctaatcttacctgttcag | |
| Primer O1 | ggtaagattagcagaatgagctagcatgactggtggac | |
| Primer O2 | tggaagtccatgctgtggtgatggtgatgatgcatatgtatatctccttcttaaagttaa | |
| Gibson assembly of gp94 C-term expression construct | ||
| Primer I1 | ctttaagaaggagatatacatatgcatcatcaccatcaccacgacccggaacgggtc | |
| Primer I2 | caccagtcatgctagctcattctgctaatcttacctgttc | |
| Primer O1 | gacccgttccgggtcgtggtgatggtgatgatgcatatgtatatctccttcttaaag | |
| Primer O2 | gaacaggtaagattagcagaatgagctagcatgactggtg | |
| PCR within and across Alexphander gene boundaries | Forward | Reverse |
| gene 7 | gtgagcatggacttccac | tcattctgctaatcttacctgttc |
| gene 94 | atggctgacatttcacgttcc | ttagctgccatccgggac |
| gb 1 91–92 | cacattgaccgggccaaag | ctggttgggttcagactgc |
| gb 92–93 | caccgagcattccaccgac | cctgaacatcgctttctgttcc |
| gb 93–94 | gaatgccccattcaaga | gcaagtcgatctgcttgcg |
| gb 94–95 | gacgcaacgtgaccgcc | gaacgccaccatggatcgttc |
| gb 95–96 | ctttcgggtgcatctcaacg | gtccaacagtttctccgcag |
| qPCR within gene boundaries | ||
| gene 7 | ggctgacatttcacgttccg | tcgaacacagtcgatccctt |
| gene 94 | ctccgaagaatcctggcctg | tcttttctatctggccggcg |
Disclaimer/Publisher’s Note: The statements, opinions and data contained in all publications are solely those of the individual author(s) and contributor(s) and not of MDPI and/or the editor(s). MDPI and/or the editor(s) disclaim responsibility for any injury to people or property resulting from any ideas, methods, instructions or products referred to in the content. |
© 2024 by the authors. Licensee MDPI, Basel, Switzerland. This article is an open access article distributed under the terms and conditions of the Creative Commons Attribution (CC BY) license (https://creativecommons.org/licenses/by/4.0/).
Share and Cite
Chong Qui, E.; Habtehyimer, F.; Germroth, A.; Grant, J.; Kosanovic, L.; Singh, I.; Hancock, S.P. Mycobacteriophage Alexphander Gene 94 Encodes an Essential dsDNA-Binding Protein during Lytic Infection. Int. J. Mol. Sci. 2024, 25, 7466. https://doi.org/10.3390/ijms25137466
Chong Qui E, Habtehyimer F, Germroth A, Grant J, Kosanovic L, Singh I, Hancock SP. Mycobacteriophage Alexphander Gene 94 Encodes an Essential dsDNA-Binding Protein during Lytic Infection. International Journal of Molecular Sciences. 2024; 25(13):7466. https://doi.org/10.3390/ijms25137466
Chicago/Turabian StyleChong Qui, Emmanuel, Feben Habtehyimer, Alana Germroth, Jason Grant, Lea Kosanovic, Ivana Singh, and Stephen P. Hancock. 2024. "Mycobacteriophage Alexphander Gene 94 Encodes an Essential dsDNA-Binding Protein during Lytic Infection" International Journal of Molecular Sciences 25, no. 13: 7466. https://doi.org/10.3390/ijms25137466
APA StyleChong Qui, E., Habtehyimer, F., Germroth, A., Grant, J., Kosanovic, L., Singh, I., & Hancock, S. P. (2024). Mycobacteriophage Alexphander Gene 94 Encodes an Essential dsDNA-Binding Protein during Lytic Infection. International Journal of Molecular Sciences, 25(13), 7466. https://doi.org/10.3390/ijms25137466

